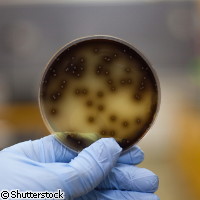

Non-conventional yeasts promise big taste with fewer calories
A new culture of opportunities is being created for beer, cheese, yoghurt and wine. Reliable flavour notes and the health-promoting benefits of probiotics go hand in hand with yeast cultures being developed by a new consortium, Cornucopia, coordinated by Professor Jure Piskur of Lund University in Sweden and financed with EUR 3.4 million from the EU. As a molecular biologist, Professor Piskur has studied different aspects of yeasts for many years. This group of single-celled organisms is widespread in nature, colonising rapidly in fruits like sugar-laden grapes. Some species of yeast turn sugars into alcohol and carbon dioxide in spontaneous fermentation, which has been used for centuries in the production of beer and wine. Fermentation is a time-tested method of making foods more easily digestible by 'unlocking' the nutrients within. Yeasts and probiotic bacteria thereby produce easily digestible foods that are high in nutritional value. For example, friendly bacteria known as lactobacilli flourish in fermented foods such as cheese and yoghurt and help produce short-chain fatty acids that support the body's immune system. 'A large benefit for [the food] industry in the EU and worldwide will be our intensive screening of non-conventional yeasts for possible beneficial traits which can be introduced into foods,' explained Professor Piskur. 'Biodiversity is an alternative approach to genetically modified yeasts. By characterising new species found in nature we will increase the diversity and number of yeasts used for industrial purposes.' A few decades ago, fermentation was carried out using a wide variety of naturally occurring yeasts. Today, the use of industrial yeasts is preferred over natural fermentation because the process is easier to control. However, if biodiversity were introduced in a controllable way, we could expect new aromas and flavours. 'There is a great interest in producing light beer with more flavour, and we hope that new species of yeast can contribute to this,' said Professor Piskur. The consortium's research activities are expected to provide new insights into yeast biodiversity (it is estimated that less than one tenth of yeasts are known) and yeast evolution. Under the microscope, different kinds of yeast seem very similar to each other, but actually this is not the case. Yeasts have been around for so long that they have managed to develop a genetic variation between different species that is larger than the evolutionary difference between fish and humans. Therefore, they are good models for understanding all forms of life, from genes to species, and the processes of evolution.
Countries
Sweden